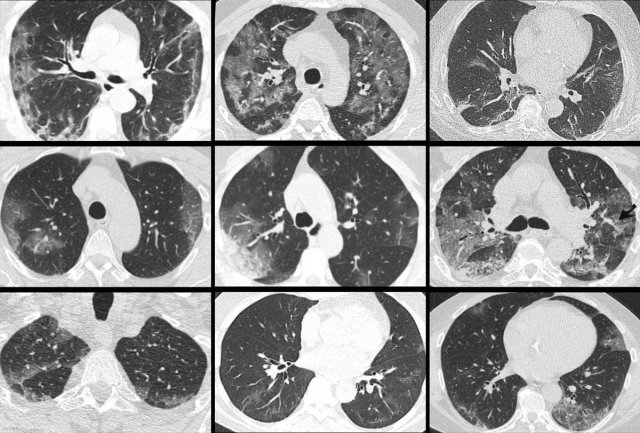

COVID-19 Differential Diagnosis
This pictorial essay presents the differential diagnosis, mimickers and overlapping CT features of COVID-19.
Performance of imaging in accurate prediction of disease depends on the likelihood of disease before the test was done.
If regional COVID-19 prevalence is high, the likelihood of SARS-CoV-2 infection is substantial in a patient with fever, dyspnea and an abnormal CT.
This likelihood changes if clinical signs are less suspicious, or if regional prevalence of COVID-19 is low.
Introduction
During the peak of the first wave of COVID-19 the a priori probability that patients, who came to the hospital with dyspnoe, coughing and fever, actually had COVID-19 was high especially if they have an abnormal chest-CT.
The images are all of patients with proven COVID-19 infection.
The CT's were classified as CO-RADS 5, which indicates a very high probability of COVID-19.
Chest CT can be helpful in the diagnosis of COVID-19 in hospitalized patients as an adjunct to PCR testing and serology.
The CO-RADS classification uses features of COVID-19 on chest CT to indicate the likelihood of COVID-19 pulmonary involvement based on CT imaging (ref Prokop et al).
Click here for more information about CO-RADS.
The CO-RADS classification is accurate in the clinical setting of hospitalized patients with high clinical suspicion of COVID-19 and symptom duration of more than 2 days (ref Schalekamp et al).
The performance of the CO-RADS classification decreases in patients without typical complaints of COVID-19 (ref), short symptom duration, and in patients with overlapping or pre-existing pulmonary disease.
In those cases we have to consider other diseases in the differential diagnosis.
The differential diagnosis of COVID-19 can be arbitrary divided into 3 subgroups:
- Groundglass mimickers
There is no real ground-glass but high density lung as a result of insufficient inspiration or normal lung looking like ground-glass because it is next to hypoperfused black lung due to vasoconstriction - Differential diagnosis
Many diseases that may look like COVID-19, but you should be able to find the differences by combinding CT and clinical findings. - Overlapping diseases
Diseases of the lung that have the exact pattern as COVID-19. Distinction can only be made with clinical parameters.
It is therefore important to take the appropriate clinical setting into account when applying CO-RADS, as a false positive CT-result may result in unnecessary treatment and isolation.
In addition, framing bias should be avoided by taking the differential diagnoses of COVID-19 CT signs into consideration and to correlate these to the clinical history of the patient.
Groundglass mimickers
Diffuse high density of the lung parenchyma can be caused by inadequate inspiration.
Inadequate inspiration
Notice the presence of inward bowing of the posterior membrane, indicative of inadequate inspiration.
Repeat examination showed normal parenchymal density (not shown).
Mosaic attenuation
Mosaic attenuation of lung parenchyma based on multifocal hypoperfusion or hypoventilation can mimic ground-glass opacities, but is fundamentally distinct.
Here, it is the low density pulmonary parenchyma that is abnormal.
It is caused by bronchopathy with hypoventilation and secondary hypoxic vasoconstriction.
The relatively high density parenchyma is normal.
Differential diagnosis
Pulmonary cardiogenic edema
Pulmonary cardiogenic edema presents with bilateral ground-glass opacities reflecting extravascular fluid in the alveolar spaces.
These ground-glass opacities are typically more centrally distributed with sparing of the peripheral parenchyma and do not fulfill the complete obligatory COVID-19 feature of location of ground glass close to the pleural surfaces.
In addition, distribution of edema can be gravity dependent, which can be appreciated on sagittal reconstructions.
 Pulmonary cardiogenic edema with centrally distributed groundglass, diffuse vascular enlargement, lymphnode enlargement and bronchial cuffing.
Pulmonary cardiogenic edema with centrally distributed groundglass, diffuse vascular enlargement, lymphnode enlargement and bronchial cuffing.
Accompanying signs suggestive of cardiogenic edema:
- Interlobular septal thickening
- Diiffuse vascular enlargement
- Lymph node enlargement
- Structural cardiac pathology
- Pleural fluid
- Clinical presentation of the patient
Pulmonary infarctions
Infarctions secondary to pulmonary emboli cause peripheral densities adjacent to the pleural surfaces.
Although these densities in part consist of ground-glass opacities, especially in the early stage, infarctions are frequently more peripheral, triangular and dense.
The images show:
- Central pulmonary embolism.
- Corresponding perfusion defects at subtraction iodine mapping.
- Peripheral, triangular pulmonary opacities in the vascular territories.
Alveolar hemorrhage
Bilateral and confluent airspace opacities caused by diffuse alveolar hemorrhage such as in e.g. systemic lupus erythomathosus on this image are distributed more along the bronchovascular bundles, and predominantly spare the peripheral pleural surfaces and costophrenic angles.
These opacities should resolve in weeks if bleeding does not recur.
The image shows alveloar hemorrhage with patchy groundglass along the bronchovascular bundles in a patient with secondary vasculitis in systemic lupus erythemathosus.
In COVID-19 the groundglass is more peripheral and diffuse.
More chronic or subacute hemorrhage causes crazy paving and fibrosis.
In addition, clinical presentation including fever, cough and leukocytosis are less common in patients with alveolar hemorrhage, although the clinical presentation of diffuse pulmonary hemorrhage remains highly variable.
Only approximately 2/3 of patients have hemoptysis
Eosinophilic pneumonia
Eosinophilic pneumonia can also present with fever and cough just like COVID-19.
On CT it presents like COVID-19 with peripheral ground-glass and consolidations, with or without a crazy paving pattern, which makes is very hard to distinghuish from COVID-19 on CT alone.
Differentiation from COVID-19 is possible based on:
- Clinical presentation with slow onset of symptoms
- Association with asthma
- Eosinophilia in bronchioalveolar lavage and blood samples
- Mainly, and more strictly upper lung zone distribution
 Drug-induced pneunmonitis with groundglass, reticulation, crazy paving and consolidations (left), which resolved after drug withdrawal (right).
Drug-induced pneunmonitis with groundglass, reticulation, crazy paving and consolidations (left), which resolved after drug withdrawal (right).
Drug-induced pneumonitis
Drugs can cause CT patterns similar to confirmatory patterns of COVID-19, including ground glass, peripheral consolidations, crazy paving and organizing pneumonia patterns.
The appropriate clinical setting of potentially pneumotoxic drugs and clear improvement after drug withdrawal (right) helps in suggesting this differential diagnosis.
A list of pneumotoxic drugs and the findings on CT is found on www.pneumotox.com.
Radiation pneumonitis
Inflammatory and fibrotic changes associated with radiotherapy can cause peripheral ground-glass and consolidations in the area of the radiation therapy field.
However, bilateral organizing pneumonia outside the radiation field can also occur, mimicking one of the confirmatory feature of COVID-19.
Correlation with the radiotherapy field and stationary location of abnormalities over time can virtually always confirm radiation pneumonitis.
Hypersensitivity pneumonitis
Ground glass opacities in hypersensitivity pneumonitis (HP) are also bilateral, but show a more geographical pattern.
In addition, HP has other features uncommon in COVID-19:
- Centrilobular nodules
- Headcheese sign” with a mixture of lobules with ground glass, normal density parenchyma, and air trapping
- Clinical presentation with a history of exposure to sometimes unknown antigens
- HP patients can develop fibrotic changes in a later stage.
The image shows typical bilateral groundglass opacities in hypersensitivity pneumonitis with head cheese sign: a mixture of ground glass, normal density parenchyma and air trapping (circle).
NSIP
Other interstitial lung diseases, such as nonspecific interstitial pneumonia can present with peripheral ground glass opacities, which can simulate COVID-19.
This patient had nonspecific interstitial pneumonia and presented on CT with faint ground glass resembling cellular and, to some extent, fibrotic interstitial disease.
Differentiation from COVID-19:
- The opacities are not demarcated
- No vascular thickening
- Mostly stable over time
- Clinical presentation is distinct from infection.
 Groundglass and consolidations resembling extensive, bilateral non-mucinous invasive adenocarcinoma and adenocarcinoma in situ.
Groundglass and consolidations resembling extensive, bilateral non-mucinous invasive adenocarcinoma and adenocarcinoma in situ.
Adenocarcinoma
Especially adenocarcinoma and its precursors can present with pure ground glass opacities with or without solid components, depending on the degree of invasiveness.
Multifocal adenocarcinoma in situ can present as bilateral ground glass opacities, which might look like COVID-19.
Here, distribution is different from COVID-19, with a more geographical and diffuse distribution and no peripheral predominance.
Alveolar proteinosis
Alveolar proteinosis is a rare condition, frequently associated with elevated lactate dehydrogenase, antibodies against granulocyte-macrophage colony-stimulating factor and broncheoalveolar fluid findings typical for alveolar proteinosis.
Crazy paving in alveolar proteinosis is much more diffuse than in COVID-19, with incidental lobular or geographic sparing, and is frequently disproportional with severity of complaints.
Overlapping diseases
With overlapping diseases we mean diseases of the lung that have the exact pattern as COVID-19.
Distinction can only be made with clinical parameters.
 Organizing pneumonia. LEFT typical peripheral and central peribronchiolar consolidations with central airway dilatation. RIGHT post treatment
Organizing pneumonia. LEFT typical peripheral and central peribronchiolar consolidations with central airway dilatation. RIGHT post treatment
Organizing pneumonia
Patterns compatible with organizing pneumonia commonly occur in COVID-19.
It is regarded as a confirmatory pattern, reflecting a later stage in the temporal evolution of the parenchymal abnormalities.
This pattern in COVID-19 overlaps with organizing pneumonia due to other causes with typical peripheral and central peribronchiolar consolidations and central airway dilatation (figure).
The lung abnormalities decreased after treatment with corticosteroids.
 Influenza pneumonia. bilateral groundglass with central distribution and centrilobular groundglass nodules.
Influenza pneumonia. bilateral groundglass with central distribution and centrilobular groundglass nodules.
Influenza pneumonia
Viral pneumonias show overlapping features on CT.
Influenza virus infection can result in bilateral ground-glass opacities, consolidations and crazy paving that appear similar to COVID-19.
Typical features of influenza are:
- Mucoid airway impaction
- Linear opacities
- Central distribution (as shown in these two cases)
In addition, vessel thickening and upper lobe involvement seem to occur more frequently in the abnormal COVID-19 parenchyma than in other viral pneumonias.
Pneumocystis pneumonia
Pneumocystis pneumonia also causes bilateral ground-glass and in later stages consolidations with or without crazy paving.
However, this frequently occurs in a more central distribution than in COVID-19, and only in immunocompromised patients.
PCP is furthermore associated with pulmonary cysts and spontaneous pneumothoraces, although pneumothoraces and bullae also present in a small minority of hospitalized COVID-19 patients.
 ARDS. Bilateral, in part gravity dependent groundglass with atelectasis, and pleural fluid in a patient who underwent a gastro-esophageal resection.
ARDS. Bilateral, in part gravity dependent groundglass with atelectasis, and pleural fluid in a patient who underwent a gastro-esophageal resection.
Adult respiratory distress syndrome
Diffuse alveolar damage can also show peripheral ground-glass, consolidations and crazy paving, which can be similar to the alveolar damage in patients with COVID-19 (left), but also more gravity dependent reflecting permeability edema (right).
ARDS can only occur in the appropriate setting, such as in a postoperative situation or in case of prolonged mechanical ventilation.
However, ARDS can concomitantly occur with COVID-19 in ICU patients.
Special thanks to
Lauran Stoger, Jet Quarles van Ufford, Ludo Beenen, Hester Gietema and the cardiothoracic radiologists of Radboud UMC including Jesse Habets, Miranda Snoeren, Bram Geurts and Steven Schalekamp.